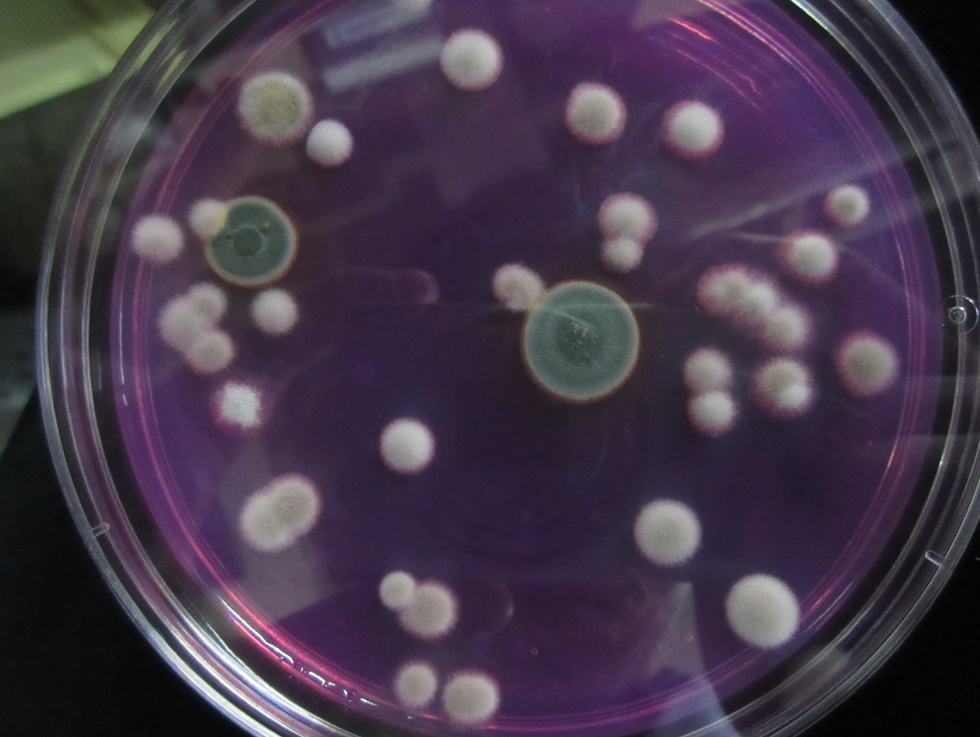
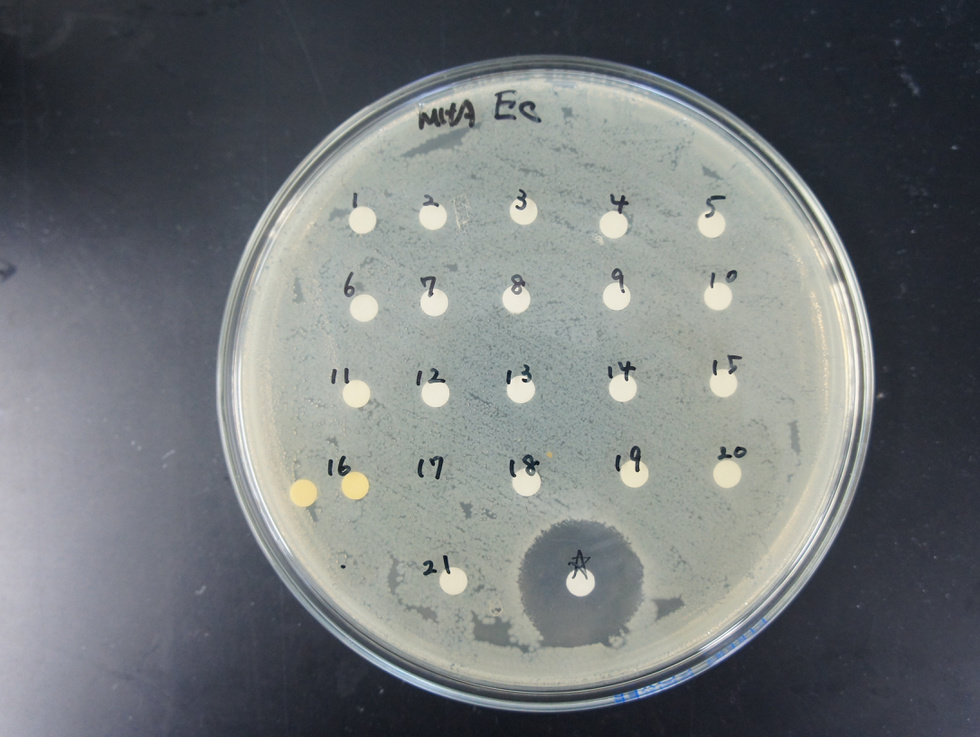

アウトライン

天然資源のサンプリング
微生物、海洋生物や植物などの天然素材を求めて、フィールドワークへ
微生物・海洋生物・植物ライブラリ
集めた天然素材をライブラリー化し、生物活性物質のスクリーニングに利用

生物活性物質のスクリーニング
天然資源ライブラリの中から、感染症やがん、生活習慣病などの薬の種 (シード) となる可能性のあるものを調査

生物活性物質の単離精製
スクリーニングで選択されたサンプルから、目的とする化合物を単離精製

生物活性物質の構造解析
様々な機器分析データから、化合物の構造を明らかに

天然有機化合物ライブラリ
希少価値の高い天然有機化合物を保管し、オリジナルの化合物ライブラリを作製
スクリーニング系の紹介

カイコ感染症モデル
カイコを感染症モデルとして利用した簡易的な in vivo スクリーニング

PTP1B 阻害薬
糖尿病治療薬、抗がん薬への応用
抗菌・抗真菌薬
様々な感染症治療薬への応用
その他

ケミカルエピジェネティクスに基づいた新規生物活性物質の創出

高濃度ハロゲン化物塩耐性変異糸状菌を用いた物質生産能の拡大

特殊培養条件による新規物質の取得

LCMS を利用した希少微生物・海洋生物の代謝産物の網羅的解析
*詳細については順次アップロードしていきます。